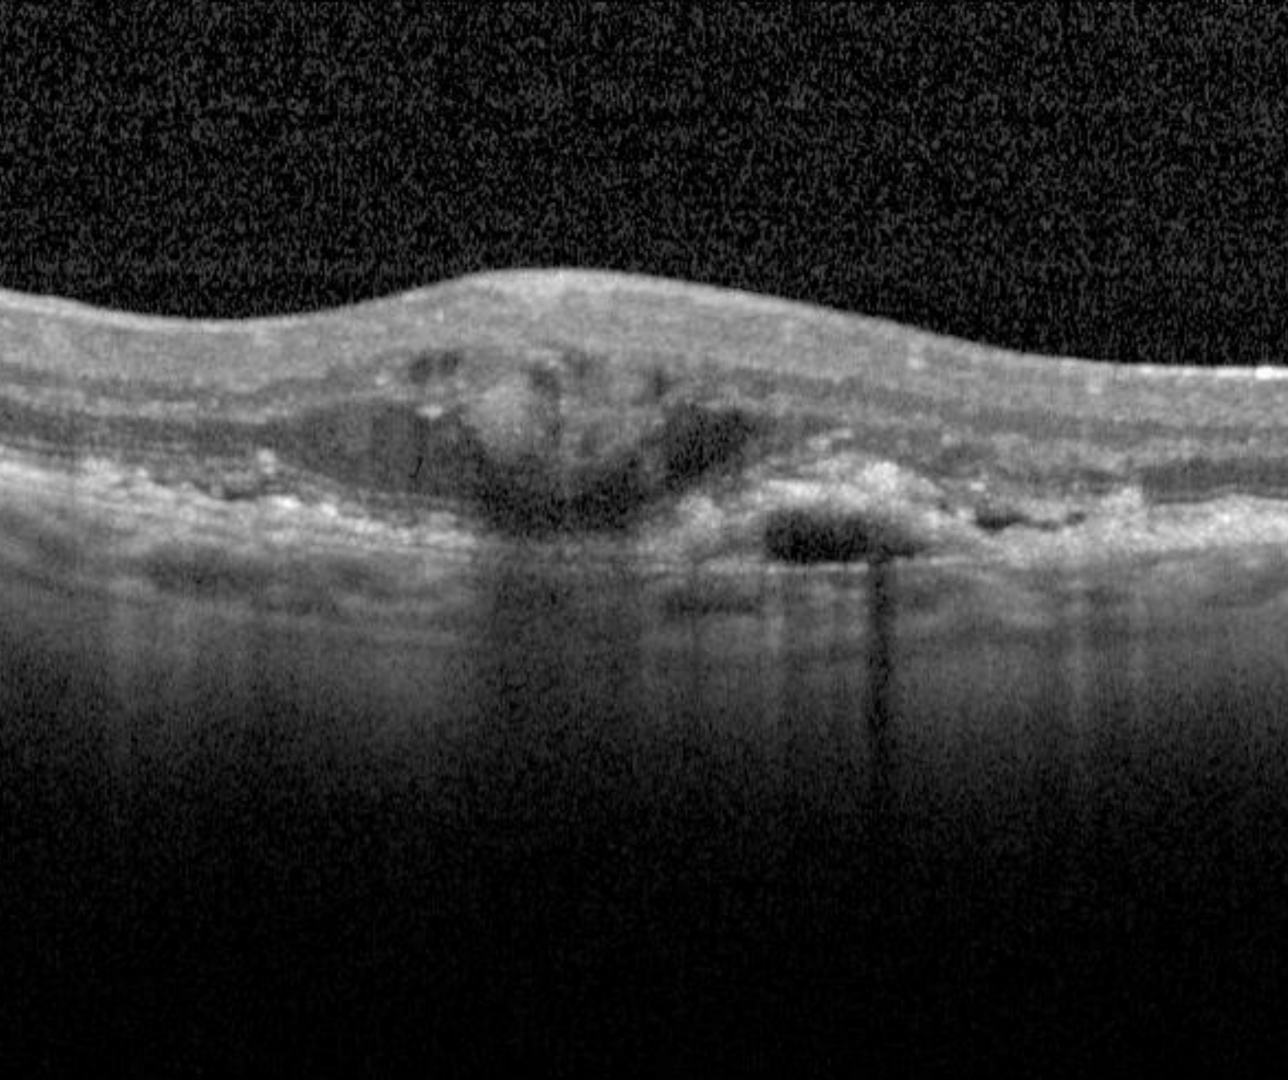

Overview
Neovascular AMD results from a process of angiogenesis where the formation of new blood vessels result in subretinal and/or sub-RPE fluid, haemorrhage and in latter stages, disciform scarring. This stage of AMD can result in significant vision loss.
Clinically, macular neovascularisation may appear as subtle, green-grey or pink-yellow lesions, however they are often difficult to detect on funduscopic examination alone.
Some key findings on OCT imaging indicating the likely presence (but are not a definitive diagnosis) of neovascular membrane include:
- RPE detachments - these present as broad elevations of the RPE band anterior to Bruch's membrane with hypo- or mixed internal reflectivity
- Intraretinal, subretinal or sub-RPE fluid
- Scarring or fibrin like deposits
- Subretinal haemorrhage and/or
- Hard exudates
Fundus autofluorescence (FAF) may be increased in the areas of subretinal fluid or reduced in the presence of haemorrhage, exudates and fibrovascular membranes however neovascular AMD can also present with normal or near normal FAF
Case Examples
-
Case 1
A 90 year old Caucasian male with central distortion on Amsler grid and best corrected visual acuity of 6/12- (20/40-).
-
Case 2
A 74 year old Caucasian male with best corrected visual acuity of 6/6- and central distortion on Amsler grid testing in the right eye.
-
Case 3
A 69 year old Caucasian male with right eye best corrected visual acuity counting fingers at 50cm.
-
Case 4
This case illustrates progression from intermediate AMD to late (neovascular) AMD.
After baseline imaging was performed at the Centre, the patient was referred back 18 months later for follow up. At baseline, the patient's best corrected acuity was 6/7.5- (20/25-) and at the follow up visit, visual acuity was 6/9.5 (20/32).
Differential diagnosis
References
Ferris, CP. Wilkinson, AB, Chakravarthy, U. Chew, E. Csaky, K. Sadda, SR. (2013) Clinical Classification of Age-related Macular Degeneration, Ophthalmology, Volume 120, Issue 4, Pages 844-851.
Ly, A. Yapp, M. Nivison-Smith, L. Assaad, N. Hennessy, M. Kalloniatis, M. (2018) Developing prognostic biomarkers in intermediate age-related macular degeneration: their clinical use in predicting progression. Clin Exp Optom. 101(2):172-181.


